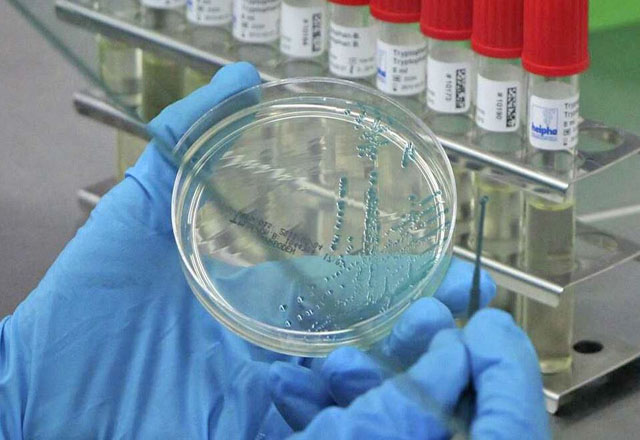

Destacado
Caída de helicópteros de la Marina han sido accidentes, reitera AMLO
Andrés Manuel López Obrador aseguró que todos los casos de caída de helicópteros durante su gobierno han sido accidentes y ninguno tuvo alguna “En todos los casos sí les puedo decir que han si
leer másDirectora del DIF, Nuria Fernández, fue amenazada hace 3 meses: AMLO
El presidente Andrés Manuel López Obrador reveló que Nuria Fernández, directora del Sistema Nacional para el Desarrollo Integral de las Familias (DIF), fue amenazada hace tres meses y tuvo que rec
leer másTaxistas de la CROC actualizan su flotilla
La Confederación Revolucionaria Obrera y Campesina se deslinda de cualquier posible manifestación que se haga contra la disposición del gobierno federal de prohibir el servicio de transporte públi
leer másAceleran legalización de autos “chocolate”
Hoy se pondrá en servicio el módulo del Registro Público Vehicular en el Centro de Convenciones Mundo Nuevo para darle celeridad a la legalización de los llamados autos “chocolate”, estimándo
leer másSSA emite alerta para evitar posibles casos de cólera
La Secretaría de Salud (SSa) emitió una alerta a las unidades médicas del país, para recomendarles aplicar un protocolo a personas que lleguen de Haití, donde se han detectado casos de la enferme
leer másEU anuncia 240 millones de dólares para que los países americanos acojan a migrantes
Lima.- El secretario de Estado de Estados Unidos, Antony Blinken, anunció este jueves que su país destinará otros 240 millones de dólares en ayuda humanitaria para que los países del continente a
leer másMéxico y EU sostendrán reunión de seguridad la próxima semana
El canciller Marcelo Ebrard informó que la próximo 13 de octubre se reunirán funcionarios de seguridad y justicia de México y Estados Unidos, incluyendo a las secretarios de Defensa, Marina y Guar
leer másPadres denuncian que hombre armado llegó a escuela de Ciudad Victoria; Policía atiende llamado
Padres y madres de familia de la escuela primaria Club Rotario de Ciudad Victoria piden el apoyo de las autoridades pues hay un padre de familia que los mantiene en la zozobra constante, ya que amenaz
leer másMéxico anuncia una segunda demanda contra los gigantes de las armas en EE UU
México hará un segundo intento por sentar en el banquillo de los acusados a los principales fabricantes de armas de Estados Unidos. Así lo ha adelantado este miércoles el secretario de Relaciones
leer másEncuentran a artesanos de Puebla reportados como desaparecidos en Tamaulipas
Los artesanos de Puebla que habían sido reportados como desaparecidos ya se encuentran de regreso en sus comunidades sanos y salvos, de acuerdo con un reporte del gobierno de Tamaulipas. La Secretar�
leer más